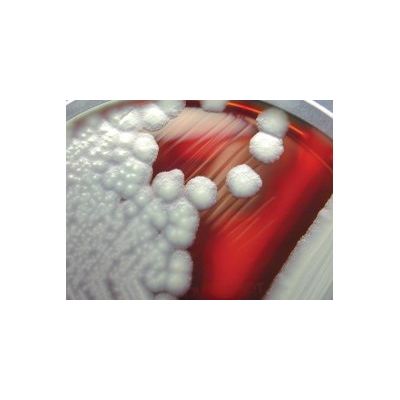
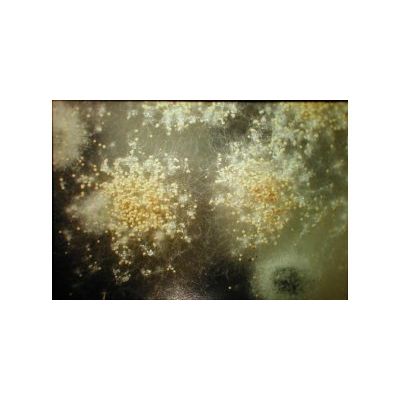

Aerobiology Laboratory Associates, Inc. services
USP 797
USP 797 is designed for health care institutions, pharmacies and other related facilities to insure the sterilization of drugs that are used in compounding sterile preparations. The environmental monitoring and the microbial evaluation of staff"s sterile techniques in compounding sterile preparations (CSPs) is critical to patient care. All locations of Aerobiology are skilled in enumeration and identification of bacteria and fungi in air samples, surface samples, glove samples and can assist in developing a microbial monitoring program for compliance with USP 797.
Water Testing
Aerobiology Laboratory provides comprehensive water testing services for the detection of waterborne pathogens. Our services include cultures for the detection of Legionella species, hospital waterborne pathogens such as Pseudomonas, Mycobacterium and Acinetobacter, Heterotrophic Plate Count, and E. coli, fecal coliforms and Enterococcus, sulfate reducing bacteria, nitrifying bacteria and iron bacteria. Our experienced staff can assist in developing a comprehensive water testing program. Aerobiology is a CDC Elite certified laboratory and an environmental microbiology accredited laboratory by AIHA.
Indoor Air Quality
Aerobiology Laboratory Associates, Inc. has provided microbial indoor air quality services for over fourteen years. Services include bacterial and fungal testing from air, water, surfaces and bulk material samples. Aerobiology Laboratory was one of the first laboratories to be accredited for environmental microbiology by the American Industrial Hygiene Association. Along with our dedication to quality, our staff prides itself on our customer support. As reflected in our passion, we are privileged to have on staff Dr. Bryce Kendrick, world renown mycologist, as our technical advisor.
Food Microbiology
The staff at Aerobiology can provide analytical testing for your raw materials and finished food products. We offer testing for a broad range of food pathogens, such as Salmonella, E. coli, Staphylococcus aureus and Listeria. In addition to evaluating the microbial bioburden we offer product performance tests such as shelf life studies, aW (water activity), titratable acidity and pH. Contact the laboratory for specialized microbial or performance testing needs.
Consulting Services
In addition to our analytical services, Aerobiology Laboratory offers consulting services to professionals that have unique or complicated projects involving clinical pathogens, such as Cryptococcus neoforms, or Mycobacterium species, target organisms, such as Helicobacter pylori, unique niche organisms, such as sulfate-reducing bacteria and event related building IAQ with occupant exposure situations, such as a black water event involving E. coli/fecal coliforms and Enterococcus. Contact the laboratory and discuss the details of your assessment with experienced microbiologists who have an extensive background in clinical and environmental microbiology.
Product Testing And Validation
Aerobiology Laboratory provides Product Testing and Validation for your finished or raw product in accordance with ASTM, JIS, AATCC, USP, AOAC and EPA methods. Testing methods provide information on performance, antimicrobial activity, growth properties , and product effectiveness. The staff at Aerobiology is experienced in developing protocol challenges to evaluate the effectiveness during the development stages of the material. Contact the laboratory to discuss the challenge of your product or material.
Analysis And Testing
Bacterial Analysis
We offer a full menu of viable bacteria (HAI pathogens, MRSA, Mycobacterium and environmental bacteria) and viable fungi (Aspergillus, Penicillium, Cryptococcus, Stachybotrys and environmental fungi). In addition to viable analysis we also offer a full range of non-viable testing (spore traps, tapes and surface directs and bulk directs) with a variety of TAT. We are CDC Elite certified for Legionella analysis and in addition, we also perform Sewage Screens, HPC and E.coli P/A on drinking water and non-potable water sources. Our Virginia and Denver lab are NVLAP accredited for bulk PLM asbestos containing material.
Fungal Analysis
We offer a full menu of viable bacteria (HAI pathogens, MRSA, Mycobacterium and environmental bacteria) and viable fungi (Aspergillus, Penicillium, Cryptococcus, Stachybotrys and environmental fungi). In addition to viable analysis we also offer a full range of non-viable testing (spore traps, tapes and surface directs and bulk directs) with a variety of TAT. We are CDC Elite certified for Legionella analysis and in addition, we also perform Sewage Screens, HPC and E.coli P/A on drinking water and non-potable water sources. Our Virginia and Denver lab are NVLAP accredited for bulk PLM asbestos containing material.
Legionella Analysis
Legionella is a bacterium that is the agent of Legionnaire"s disease and Pontiac fever. It is primarily caused by Legionella pneumophila and is one of the most challenging building acquired diseases in the industrial hygiene community. According to CDC, over a year 8000 - 18,000 cases are estimated to be caused by Legionella.
Non Culturable Analysis (Non-Viable)
Non-culturable analyses are done by direct microscopic examination of air swabs, tapes or bulk material. This allows for complete characterization of the fungal spores, fruiting structures, hyphal elements and other fungal fragments in addition to pollen grains, elevated levels of bacteria, and identification of select non-biological materials. This total fungal characterization allows identification of fungi that may be both viable upon culture and those that would not be viable upon culture. The advantages of direct reads are that it can be performed quickly, it is useful as a general screening tool and as an assessment tool for post-verification.